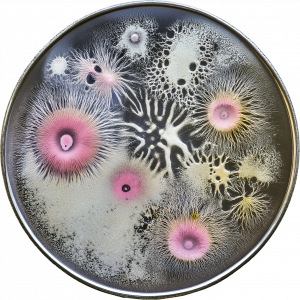

Aga Pokrywka
Ariella Vidach & Claudio Prati
Calin Segal
Celine Daemen & Aron Fels in collaboration with Studio Nergens
César Escudero Andaluz
Éva B. Csonka
Ida Hiršenfelder
Ivan Iovine
Loïs Soleil
Mohsen Hazrati
Noemi Iglesias Barrios
Paolo Cirio in collaboration with Kilton Hopkins & Milanthi Sarukkali
sikau/půbalová (Dr. Lea Luka Tiziana Sikau and Denisa Půbalová)
Thomas Garnier
Where Dogs Run in collaboration with Sergey Mashkov

Adriana Knouf in collaboration with Ramberto Gozalie

Agata Konarska in collaboration with Jakub Kosecki

Ali Akbar Mehta in collaboration with Jernej Čuček Gerbec

Andreas Zingerle in collaboration with Linda Kronman

Benedikt Terwiel in collaboration with ANOHNI

Christian Skjødt Hasselstrøm in collaboration with Kaj Nielsen

Dr. masharu in collaboration with Sil Zeigarnik, Evy de Nijs, Emma Polman, Sophia Komarov-Reinisch

Fleur Melbourn

Johanna Bruckner in collaboration with Ann-Kathrin Kluss and Im Kanokporn Vorapharuek

Karolina Żyniewicz in collaboration with Mihael Giba and Gjino Šutić

Leon van Oldenborgh in collaboration with Róbert Rampáček

Luiz Zanotello in collaboration with Ricardo Vieira
Lukas Truniger in collaboration with Bruce Yoder

Rosemary Lee in collaboration with Alexia Achilleos

SOAP

Vivien Roussel in collaboration with Pierre-Alexis Ciavaldini

Annelie Berner in collaboration with Monika Seyfried

Bethan Hughes in collaboration with Diego Flórez

Carl Emil Carlsen in collaboration with Anna Fišere

Dasha Ilina in collaboration with Supisara Burapachaisri

Davor Sanvincenti in collaboration with Joana Patrão and Adriana Romero

Dorotea Dolinšek in collaboration with Barbara Sušnik

Emanuel Gollob in collaboration with Daria Bogdan and Mar Sala Romagosa

Endi Tupja in collaboration with Klodiana Millona

Maria Smigielska & Compmonks

Marisa Satsia in collaboration with Aisen Caro Chacin

Me AndOther Me (Anna Pompermaier & Cenk Güzelis) in collaboration with Valdemar Danry

Mónica Rikić in collaboration with Gema FB Martín

Nicolas Gourault in collaboration with Lucas Azémar

Paul O´Neill in collaboration with Frank Sweeney

Tatsuru Arai in collaboration with Boris Vaitovič

Transformative Narratives (Lena Kuzmich & Tony Wagner) in collaboration with Gerard Valls Montaño, Cris Anutoiu, Martin Eichler

Alizée Armet in collaboration with Jakob Grčman

Caroline Sinders in collaboration with Trammell Hudson

Charlotte Jarvis in collaboration with Dr. Patricia Saragueta & Prof. Susana Chuva de Sousa Lopes

Juliane Jaschnow & Stefanie Schroeder in collaboration with Shoi

Leon Butler in collaboration with Peter Power

Marc Vilanova

Marleine van der Werf in collaboration with Antoine Bertin

Nadja Verena Marcin in collaboration with Alex Stachowiak

OPN Studio in collaboration with Guillermo Casado

Paula Nishijima in collaboration with Marlén López

Rosa Menkman in collaboration with Marios Isaakidis, Taietzel Ticalos and Irini Mirena Papadimitriou

Beny Wagner in collaboration with Sasha Litvintseva

So Kanno in collaboration with Akihiro Kato and Takemi Watanuki

Studio Above & Below in collaboration with Yau Fan

T(n)C in collaboration with Madeline Hall

Andrius Arutiunian

Darsha Hewitt

Flow Architecture (Annarita Papeschi & Vincent Nowak)

Gil Delindro

Liliana Zeic

Moritz Simon Geist

Nico Angiuli

Rybn.org

Silvia Rosani

Sophie Hoyle

Total Refusal

Carolin Liebl & Nikolas Schmid-Pfähler

Clusterduck Collective

Daniel Hengst

Forms of Ownership

Kasia Molga

Kat Austen

Konrad Korabiewski

Mark Farid

Martin Nadal

Stefan Laxness

uh513 (María Castellanos & Alberto Valverde)

Aay Liparoto

Andrej Boleslavský

Birk Schmithüsen

disnovation.org

Florent Di Bartolo

Joana Moll

MAEID (Daniela Mitterberger & Tiziano Derme)

Marco Barotti

Margherita Pevere

Quimera Rosa

Wouter Moraal

Adam Donovan & Katrin Hochschuh

Aleksandra Niemczyk

Anna Dumitriu & Alex May

Anna Ridler

Chloé Galibert-Laîné & Kevin B. Lee

Doug Fishbone

Karen Lancel & Hermen Maat

Kentaro Kumanomido & Teaque Owen

Robertas Narkus

Robertina Šebjanič & Gjino Šutič

Taavi Suisalu

Coralie Vogelaar

Kimmo Modig

Paula Pin

Wesley Goatley
Alessandro Bertelle
Graeme Cole
Maigret

Manuel Abramovich

Tabita Rezaire

Cristina Picchi

Daniel Cockburn

Isabell Spengler

Matthew Biederman & Pierce Warnecke

Matthew Gingold

Pedro Ferreira

Robyn Moody

Soda_Jerk (Dan & Dominique Angeloro)

Verena Friedrich

Abel Korinsky

Anaisa Franco


Bernhard Hetzenauer

Daniel Ulacia

Gail Priest

Lauren Moffatt

Mónica Rikić

Steve Reinke

Anni Garza Lau

Daniel Silvo

Gabriela Monroy & Caspar Stracke

Ginan Seidl

Joaquin Segura

Martin Keil & Henrik Mayer

Txema Novelo

Zeyno Pekünlü

Amanda Gutiérrez

Dina Rončević

Florian Tuercke

Jan-Peter E.R. Sonntag

Kathrin Kur

Laura Balboa

Manon Bovenkerk

Maria Vedder

Marissa Viani Serrano

Rebecca Lennon

Rosa Menkman

Rubén Gutiérrez

Augustin Gimel & Brigitte Perroto

Linda Hilfling
Mar Canet Sola & Vavara Guljaveva
Murat Haschu
Pekka Sassi

Pim Zwier

Christian Diaz Orejarena
Emily Richardson

Jean Charles Hue

Jean-Gabriel Périot

Leopold Kessler
Maarit Suomi-Väänänen

Anna Molska & Krzysztof Franaszek

Dagmar Keller & Martin Wittwer

Karen Mirza & Brad Butler


Nika Oblak & Primož Novak

Paolo Cirio

Ran Huang

Shu Lea Cheang

Thomas Köner

Tobias Rosenberger

Don Ritter

Helene Sommer

Julio Soto & Scott Petill

Katarina Zdjelar

Kurt D'Haeseleer

Raymond Taudin Chabot

Tereza Serenová

Theo Prodromidis

Köken Ergun
Stefan Piat


Christoph Wachter & Mathias Jud

Martin Brandt

Ralph Jürgen Colmar
Tobias Sternberg

Alina Rudnitzkaya

Erik Bünger
Celine Condorelli & Bea Gibson
Charly Nijensohn

Chris Oakley
Daniela Plewe
Johannes Auer
Valerie Pavia

Dane Watkins

Dietmar Offenhuber

Chris Bowman
Greg Daville
Janine Sack
Lilia Perez Romero
Margarete Jahrmann

Martin Conrads
Catriona Grant
Dellbrügge & de Moll
Diogo Terroso
Martin House
Petko Dourmana

Sarah Miles

Lilian Jüchtern & Günter Eger
Michael Pinksy

Nina Könnemann

Rob Kennedy
Sarah Felton

Ákos Balázs, Anita Sárosi, Erika Katalia Pásztor
Benoit Maubrey

Cornelia Sollfrank

Eike Berg

Jeff Instone

Roshini Kempadoo

Sandra Schäfer
Szabolcs KissPál
Tilman Küntzel
Colin Andrews
Jessica Curry
Lotio F. aka Felicia Zeller
Péter Hecker

programm 5: Nicole Martin & Lilian Jüchtern

Beverly Hood

Caspar Stracke
Hannah Cox
Hilda Kozári

Joachim Blank & Karl Heinz Jeron
Mikko Maasalo

Paul Harrison & John Wood
Reinhold Adt

Szacsva y Pál
Teemu Mäkki
Ylitalo Jukka

Zsolt Veress

Bjørn Melhus & Julia Neuenhausen
László L. Révész
Laura Smith
Jan Verbeek
Alexander Decker & Andrea Otero
Boris Nieslony
János Sugár
Kypros Kyprianou

Mike Stubbs
Thomas Sterna
Zoltán Szegedy-Maszák